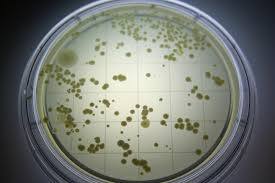
images.jpg

JavaScriptを有効にしてお使いください
JavaScriptの設定方法はこちらの検索結果を参考にしてください
マイネオユーザーがこんなにも!!さすがお江戸は規模が違う!高知の自宅だと20人程度。田舎な職場でレーダー起動したら、自分以外見当たらない。純粋にビックリでした。
メンバーがいません。
580人位だったか!
ただ、先ほど自宅で『1人発見!』で1チップを受け取ってしまいました。失敗したぁ💦
貰える条件が良くわからないので、もし貰えた方がいれば、書き込みお願いします。
https://king.mineo.jp/my/994fa82ec265c79c/reports/44390
何となく似てませんかね?(笑)大阪はマイネオの地元だから、
圧巻でしょうね。
二人はマイネオって知っているのですが
あと何人いるかな?大阪ですが、少ない気がします。
それって何かの培養ですか❓(笑)
羽田空港近くも多かったですよ🎵
バスの中でレーダーしました😆
私の家では、3~6人なので、悲しいです💦
画像は、こちらから···
https://kabi.co.jp/kabi.php?k=k26
羽田空港の周りは海と埋め立て地、道路に南は工業地帯。
住宅地はありますが、住人の数はそんなに多くないですよ(笑)
おはよーございます。
よかったぁ、ケロコロさんにも私と同じように見えていたんですね?!培養シャーレ(^.^;
私はいつも0~2点くらいしか見てませんが、皆さんの桁違いの点々を見る度に培養菌を想像してしまいます💦
昨日の日中、幕張の高速道路上では87人でした。思ったより少なかったですね。初の3桁を見られるかとワクワクしていたんですが、残念。